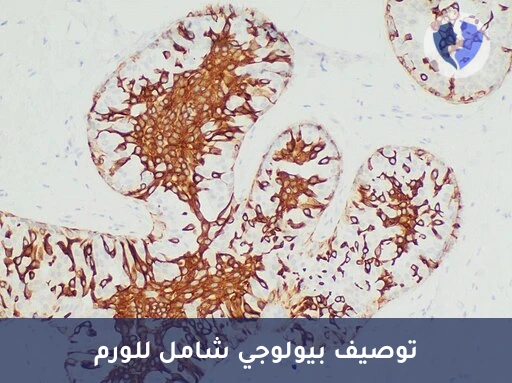
ملف بيولوجي واستشارة علاجية - تحليل واستشارة الكيمياء النسيجية المناعية (5 Markers) (IHC)

تفاصيل الخدمة
ملف بيولوجي واستشارة علاجية - تحليل واستشارة الكيمياء النسيجية المناعية (5 Markers) (IHC)
باقة استشارية علاجية شاملة تقوم على التوصيف البيولوجي المنهجي للورم باستخدام خمس علامات مناعية (IHC) تم اختيارها لتغطية المجالات الرئيسية: 1) التصنيف والتشخيص، 2) المستقبلات العلاجية (هرمونية/مستهدفة)، 3) حالة التكاثر الخلوي، 4) الاستجابة المناعية، 5) علامة تنبؤية إضافية أو للتمييز. يتم تحليل النمط الخماسي (Quintuple Profile) في سياق المبادئ التوجيهية العلاجية الحديثة (مثل NCCN، ESMO) من قبل أخصائي علم الأمراض، لإنتاج تقرير استشاري يربط مباشرة بين كل نتيجة علاجية محتملة وعلامة محددة، مع ترجيح الخيارات بناءً على قوة الدليل.